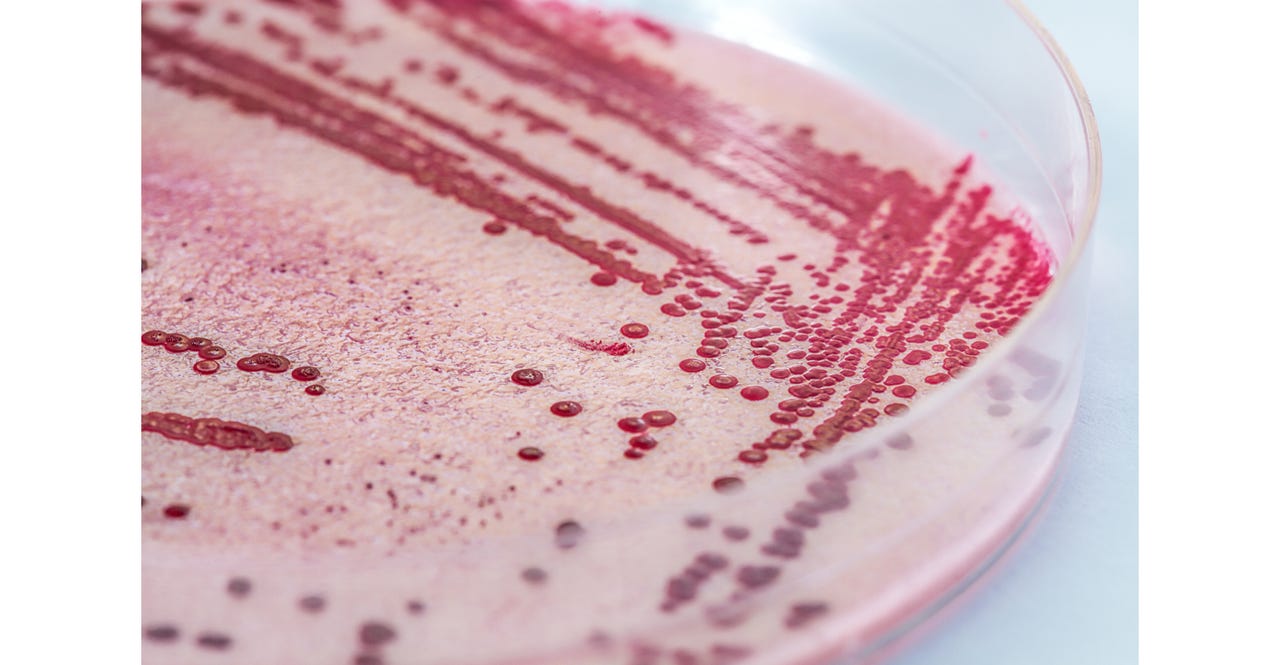
Blue light might eradicate Listeria Blue light might eradicate Listeria

Food Processors Can Now Rid Their Facilities from Listeria
Using blue light over ultraviolet light presents less risk to the user.
October 20, 2023
Blue light kills both dried cells and biofilms of the pathogen Listeria monocytogenes, a frequent contaminant of food processing facilities. Demise of L. monocytogenes occurred quickest when cells or biofilms were placed on polystyrene, a widely used, transparent form of plastic.
The research is published in Applied and Environmental Microbiology, a journal by the American Society for Microbiology.
“These results contribute to advancing our understanding of the potential of blue light to treat inert surfaces contaminated with L. monocytogenes,” said corresponding author Francisco Diez-Gonzalez, PhD, director and professor, Center for Food Safety, University of Georgia. Although biofilms of pathogens are generally powerfully resistant to being exterminated, the results suggest that blue light could effectively destroy L. monocytogenes.
In the study, the investigators deposited liquid suspensions of mixtures of five strains of L. monocytogenes on small, sterile rectangular plates made of six different materials, including polystyrene, stainless steel and silicone rubber, which were then allowed to dry. They also used similar plates to grow biofilms, which was also allowed to dry.
Investigators then shined blue light onto the biofilms and onto the dried suspensions of cells on the plates to determine the most effective combinations of doses and wavelengths, as well as the most effective surfaces on which to extirpate the pathogens.
“The application of blue light for controlling microbial contamination has the potential to offer an additional technology that could complement existing methods for disinfecting surfaces in contact with foods,” said Diez-Gonzalez, noting that blue light has been used for disinfection in hospitals. As compared to ultraviolet light, blue light offers reduced risk for the user, he said.
Fereidoun Forghani, PhD, a post-doctoral in Diez-Gonzalez's lab, kick-started the investigation when, searching for new ideas, he came across the use of blue light as a potential antimicrobial intervention to sanitize surfaces. Forghani built some blue light prototypes and produced the first preliminary results treating pure cultures of Listeria.
About the Author(s)
You May Also Like




